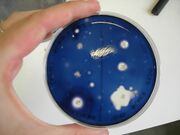

Uploads by Chapart Marie
From OpenWetWare
Jump to navigationJump to search
This special page shows all uploaded files.
| Date | Name | Thumbnail | Size | Description |
|---|---|---|---|---|
| 10:43, 16 September 2008 | Photos09092.gif (file) |  |
182 KB | |
| 10:26, 16 September 2008 | Gel51092pcr.gif (file) |  |
178 KB | |
| 10:21, 16 September 2008 | Gel51091pcr.gif (file) |  |
113 KB | |
| 09:56, 16 September 2008 | Gel31091pcr.gif (file) |  |
244 KB | |
| 09:38, 16 September 2008 | Gel21092pcr.gif (file) |  |
369 KB | |
| 09:30, 16 September 2008 | Gel21091pcr.gif (file) |  |
16 KB | |
| 08:59, 16 September 2008 | Gel11093.gif (file) |  |
77 KB | |
| 08:49, 16 September 2008 | Gel11092pcr.gif (file) |  |
580 KB | |
| 08:44, 16 September 2008 | Gel10092pcr.gif (file) |  |
307 KB | |
| 15:41, 15 September 2008 | Gel10091pcr.gif (file) |  |
84 KB | |
| 14:24, 9 September 2008 | Photosdfscontrols.gif (file) |  |
236 KB | |
| 14:20, 9 September 2008 | Gelsdgsdg.gif (file) |  |
93 KB | |
| 14:19, 9 September 2008 | 09.gif (file) |  |
93 KB | |
| 11:19, 8 September 2008 | Ge0809pcr.gif (file) |  |
79 KB | |
| 16:01, 6 September 2008 | 112Amylase.jpg (file) |  |
804 KB | |
| 16:00, 6 September 2008 | 153Amylase.jpg (file) |  |
849 KB | |
| 15:59, 6 September 2008 | PhotoNegqtiveControlAmylase.jpg (file) |  |
742 KB | |
| 15:58, 6 September 2008 | PhotoPositiveControlAmylase.jpg (file) |  |
821 KB | |
| 15:49, 6 September 2008 | PhototransfECE166.jpg (file) |  |
235 KB | |
| 15:48, 6 September 2008 | Phototrans166.jpg (file) |  |
1.15 MB | |
| 15:39, 6 September 2008 | Trans.gif (file) |  |
9 KB | |
| 19:09, 5 September 2008 | Photo3.gif (file) | |
838 KB | |
| 19:08, 5 September 2008 | Photo5.gif (file) |  |
849 KB | |
| 19:08, 5 September 2008 | Photo6.gif (file) |  |
789 KB | |
| 19:07, 5 September 2008 | Photo4.gif (file) |  |
804 KB | |
| 19:05, 5 September 2008 | Photo2.gif (file) |  |
821 KB | |
| 19:04, 5 September 2008 | Photoer.gif (file) |  |
745 KB | |
| 19:04, 5 September 2008 | Photoesr.gif (file) |  |
821 KB | |
| 18:48, 5 September 2008 | Photoesfr.gif (file) |  |
742 KB | IA771 (no zone of clearing) |
| 15:53, 5 September 2008 | Boodfg image001.gif (file) |  |
22 KB | |
| 15:03, 5 September 2008 | Photoeds.gif (file) |  |
53 KB | |
| 14:50, 5 September 2008 | Photoefr.gif (file) |  |
96 KB | |
| 14:48, 5 September 2008 | Photoed.gif (file) |  |
120 KB | |
| 14:44, 5 September 2008 | Gel5.gif (file) |  |
27 KB | |
| 14:42, 5 September 2008 | Gel4.gif (file) |  |
58 KB | |
| 14:33, 5 September 2008 | Gel3.gif (file) |  |
219 KB | |
| 14:32, 5 September 2008 | Gel2.gif (file) |  |
125 KB | |
| 14:22, 5 September 2008 | Gel1.gif (file) |  |
189 KB | |
| 13:36, 5 September 2008 | Photor.gif (file) |  |
19 KB | |
| 13:31, 5 September 2008 | Photoq.gif (file) |  |
80 KB | |
| 13:24, 5 September 2008 | Photop.gif (file) |  |
78 KB | |
| 13:20, 5 September 2008 | Photon.gif (file) |  |
16 KB | |
| 11:50, 5 September 2008 | Photom.gif (file) |  |
23 KB | |
| 11:42, 5 September 2008 | Photol.gif (file) |  |
22 KB | |
| 11:42, 5 September 2008 | Photok.gif (file) |  |
12 KB | |
| 11:33, 5 September 2008 | Photoj.gif (file) |  |
11 KB | |
| 11:29, 5 September 2008 | Photoi.gif (file) |  |
26 KB | |
| 11:25, 5 September 2008 | Photoh.gif (file) |  |
14 KB | |
| 11:21, 5 September 2008 | Photog.gif (file) |  |
15 KB | |
| 11:18, 5 September 2008 | Photof.gif (file) |  |
13 KB |